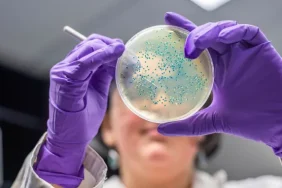
771d5e8f-60a5-4a97-b30f-14c8067f9347

Günümüzde sürdürülebilir bir gelecek için dünya genelinde çevre dostu uygulamalar öne çıkmaktadır. Bu uygulamalar arasında en dikkat çekici olanlardan biri “Sıfır Atık Hareketi”dir. Sıfır atık kavramı, atıkların azaltılması, geri dönüşümün artırılması ve doğaya zarar vermeden kaynakların etkin bir şekilde kullanılmasını amaçlamaktadır. Bu bağlamda Türkiye, bu harekete önemli bir katkı sağlayarak kendi ulusal stratejisini oluşturmuş ve uygulamaya koymuştur.
Dünyada Sıfır Atık Hareketi
Dünyanın çeşitli bölgelerinde farklı sıfır atık uygulamaları bulunmaktadır. Örneğin;
- Avrupa Birliği: 2030 yılına kadar plastik atıkların tamamen ortadan kaldırılması hedeflenmektedir. Geri dönüşüm oranlarının artırılması ve atık oluşumunun azaltılması konusunda sıkı politikalar geliştirilmektedir.
- Japonya: Kamikatsu kasabası, tamamen sıfır atık hedefi ile hareket ederek atıkların %80’inden fazlasını geri dönüştürmeyi başarmıştır.
- ABD: Bazı eyaletlerde geri dönüşüm ve kompost uygulamaları yaygın hale getirilmiştir. San Francisco, sıfır atık hareketinde öncü konumda olup, atık düşürme ve geri kazanım stratejilerini etkin bir şekilde uygulamaktadır.
Türkiye’de Sıfır Atık Hareketi
Türkiye’de sıfır atık uygulamaları, çevreyi koruma, doğal kaynakların etkin kullanımını sağlama, ekonomik kalkınmaya katkı sunma ve sürdürülebilir bir gelecek oluşturma amacıyla 2017 yılında Cumhurbaşkanlığı himayesinde resmen başlatılmıştır. Kamu ve özel sektörün ortak girişimleriyle hayata geçirilen bu harekette en öne çıkan noktalar şunlardır:
- Sıfır Atık Yönetmeliği: Kamusal ve özel sektörde sıfır atık sistemlerinin kurulmasını zorunlu hale getiren yasal düzenlemeler yapılmıştır.
- Yerel Yönetim Uygulamaları: Belediyeler, sıfır atık uygulamalarını hayata geçirerek geri dönüşüm alanları, atık ayrıştırma noktaları ve toplama sistemleri oluşturmuştur.
- Eğitim ve Bilinçlendirme: Okullarda ve iş yerlerinde sıfır atık bilinci oluşturulmakta, vatandaşlar bu konuda aktif olarak bilgilendirilmektedir.
- Ekonomik Teşvikler: Geri dönüşümü teşvik eden ekonomik destekler ve projeler hayata geçirilmektedir.
- Tarım ve Orman Bakanlığı Faaliyetleri: Tarım ve Orman Bakanlığı, sıfır atık uygulamaları kapsamında tarımsal atıkların geri dönüşümü, biyogaz tesislerinin kurulması ve sürdürülebilir tarım uygulamalarını desteklemektedir. Ayrıca orman atıklarının enerjiye dönüştürülmesi ve atık su yönetimi konularında projeler geliştirilmektedir.
Karşılaştırma: Türkiye ve Dünya
Türkiye’nin sıfır atık hareketi, Avrupa ve ABD’deki uygulamalara göre daha yeni olmasına rağmen, devletin öncülüğünde hızlı ve etkin bir şekilde yayılmaktadır. Avrupa’daki geri dönüşüm oranlarının yüksek olmasına karşın, Türkiye’de uygulanan yasal ve kurumsal düzenlemeler, kamu ve özel sektör işbirliği ile desteklenerek daha geniş kapsamda ve daha etkin çözümler sunmaktadır.
Türkiye, Japonya ve Almanya gibi ileri düzeyde geri dönüşüm altyapısına sahip ülkelerin deneyimlerinden faydalanarak kendi şartlarına uygun, yenilikçi projeler geliştirmekte ve atıkların büyük bir kısmını geri kazanma oranını artırmak için yoğun bir çaba sarf etmektedir. Son yıllarda hayata geçirilen projelerle, Türkiye’nin sıfır atık konusunda dünyada öncü bir model oluşturma potansiyeli her geçen gün daha belirgin hale gelmektedir.
Sıfır Atık Hareketinin Dünyaya Kazandıracakları
- Çevre Koruma: Plastik ve tehlikeli atıkların azaltılması ile doğa ve denizlerin temizlenmesi sağlanacak, ekosistemler korunacak.
- Ekonomik Katkı: Geri dönüşüm sektöründe yeni istihdam alanları oluşacak, ekonomiye ek gelir sağlayacak.
- Enerji Tasarrufu: Atık dönüşümü ile enerji verimliliği artacak, fosil yakıt bağımlılığı azalacak.
- Sağlıklı Yaşam: Hava, su ve toprak kirliliği azalacak, insan sağlığı olumlu yönde etkilenecek, hastalık oranları düşecek.
- Kaynak Verimliliği: Doğal kaynakların daha etkin kullanılması sağlanacak, geri dönüşüm yoluyla ham madde ihtiyacı azalacak.
- Sürdürülebilir Tarım: Tarımsal atıklar yeniden değerlendirilerek gübre ve biyogaz gibi çözümler sunulacak, gıda israfı azaltılacak.
Türkiye’nin sıfır atık hareketindeki başarısı, dünya genelinde de fark yaratabilecek bir model oluşturmaktadır. Bu hareketin daha geniş kapsamda benimsenmesi ile gelecek nesillere daha temiz ve yaşanabilir bir dünya bırakmak mümkün olacaktır.